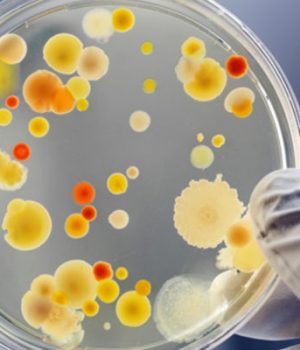
Ротавірусна-інфекція:-симптоми-та-профілактика Ротавірусна-інфекція:-симптоми-та-профілактика

Джерело: Нововолинська міська рада
Хворобу реєструють протягом усього року. Проте особливістю її як вірусного гастроентериту є підйом в осінній період з подальшим наростанням у зимово-весняний. До того ж, це захворювання може мати епідемічний характер.
Найчастіше хворіють маленькі діти. Майже кожна дитина у світі до 5-річного віку заражається ротавірусом принаймні один раз.
Симптоми захворювання переважно з’являються через 2 дні. Блювота й діарея можуть тривати від 3 до 8 днів. Особливо небезпечними для немовлят і маленьких дітей можуть бути додаткові симптоми (втрата апетиту, зневоднення).
Захворіти можуть і дорослі. У них захворювання зазвичай протікає в легкій формі з менш вираженими симптомами.
Джерелом інфекції є хвора людина. Збудник виділяється з кишківника. Інфікування відбувається фекально-оральним шляхом як безпосередньо, так і під час контакту з поверхнями і предметами, що могли бути забруднені: іграшками, підлогою, меблями, одягом тощо, а також під час вживанні їжі інфікованої ротавірусом. Інфікуватися ротавірусом можна також при будь-якому контакті з рідинами організму хворої людини, наприклад, під час чхання або контакту з дверними ручками чи іграшками, яких торкався хворий.
Інкубаційний період може тривати від 15 годин до 7 днів. Хворі скаржаться на здуття та болі в животі, нудоту, блювання, діарею з водянисто-пінистими випорожненнями яскраво-жовтого кольору, лихоманку. Також захворювання може проявлятися як ГРВІ: нежить, почервоніння в горлі, біль при ковтанні, попри те, що це виключно кишкова інфекція й не має жодного стосунку до вірусів респіраторної групи, тому ротавірусну інфекцію часто називають «кишковим грипом». Основну небезпеку являє собою зневоднення організму, що відбувається внаслідок блювоти та проносу особливо у немовлят.
Основними методами профілактики ротавірусної інфекції є вакцинація та дотримання правил особистої гігієни.
Вакцина захищає від ротавірусних гастроентеритів і розвитку тяжких форм захворювання. ВООЗ рекомендує вводити першу дозу ротавірусної вакцини якомога швидше після 6-тижневого віку. В Україні щеплення проти ротавірусної інфекції відносять до рекомендованих, тобто вакцинуватися можна власним коштом.
Неспецифічна профілактика полягає в дотриманні правил особистої гігієни (миття рук після відвідування туалету та громадських місць, перед їжею), а також правил обробки їжі і води. Овочі та фрукти необхідно ретельно мити, а під час епідемічного періоду рекомендується обдавати їх окропом. Для пиття та приготування їжі варто використовувати тільки кип’ячену воду. Особливу увагу потрібно приділяти якості молочної продукції: не можна вживати продукти сумнівного походження і з вичерпаним терміном придатності.
Якщо ротавірусну інфекцію вже виявили, то люди, які доглядають за хворими, повинні після миття рук додатково обробляти їх антисептиком. Забрудненні іграшки та поверхні необхідно мити з мийним засобом, а обробка 70% розчином етилового спирту інактивує ротавірус та попереджає його подальше передавання.
Існує загроза поширення ротавірусної інфекції в організованих дитячих колективах. Ретельне дотримання правил особистої гігієни дітьми та персоналом, а також санітарно-гігієнічного та протиепідемічного режиму – основна запорука епідблагополуччя.
Лікування гострої ротавірусної інфекції є неспецифічним і передбачає, насамперед, боротьбу зі зневодненням. При перших симптомах хвороби слід звертатись до лікаря. Підтвердити діагноз можна за допомогою швидкого тесту, придбаного в аптеці.